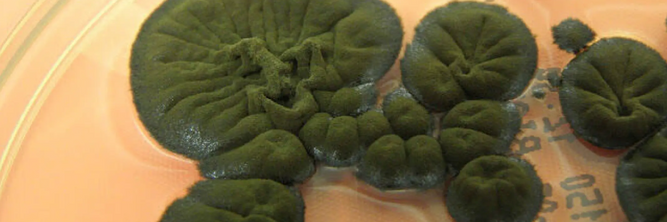
Illustrasjon av Sopp i Tsjernobyl ser ut til å kunne «spise» stråling

Nå blir trafikkbøtene dyrere
08:50
Elektroniske produkter kan spionere på deg hjemme – myndighetene advarer før julehandelen
07:16
Nytt amerikansk presidentfly forsinket til 2028
04:13
EU-landene enige om fiskekvoter
04:11
Iran tar beslag i tankskip
I går, 21:36
Ukrainske droner traff to russiske oljerigger, ifølge ukrainsk sikkerhetskilde
I går, 20:00
Konkurransetilsynet skal vurdere Telenors varslede milliardoppkjøp
I går, 17:38
EU-kommisjonen ser ut til å skrote et planlagt forbud mot fossildrevne biler
I går, 17:28
Hageplanter truer naturen ved Oslofjorden
I går, 16:00
Innspurt i fiskeriforhandlingene med Russland
I går, 15:54
Staten avviser naturhensyn – sier ja til ny vindkraft på Jæren
I går, 15:38
Equinor dropper flytteplaner
I går, 14:41
Statnett får 1,5 millioner i bot
I går, 14:38
Flere norske skogområder vernes: – 1330 truede arter
I går, 14:33
Nesten 40 grader i temperaturforskjell i Norge
I går, 13:55
Gruveselskap anker dom – mener miljøorganisasjonene må betale mer i sakskostnader
I går, 12:44
«Jernmarker» er årets ord i Danmark
I går, 12:32
Meteorologene varsler: Årets desember kan bli den mildeste i Oslo noensinne
I går, 11:33
Nationaltheatret T-banestasjon åpen igjen etter brannalarm
I går, 09:14
Dobling i antall barn som får sovemedisin på ti år
I går, 08:00


Analyse
Fusjonsfeberen raser: Nå må det briste eller bære

Bekrefter angrep:
Kan påføre Russland større skade enn droner og kryssermissiler

– Langtidsplanen er underfinansiert
Statnett får millionbot

Nye miljøkrav:
Kan koste svenske T-baner dyrt

Kommentar
Generasjon narsissist
Vivi Ringnes Berrefjord - Spaltist
Digi.no

Kina-eid selskap hjelper EU å bli uavhengig av Kina:
– Det er klart det blir kommentert på
2

– Kroppen får aldri ro

Øker produksjon av solenergi i Oslo ni prosent

Ber regjeringen kjøpe flere redningshelikoptre
Equinor droppet krav om ekstra helikopter-sjekk: – Skremmende

La fiber etter «glipp» – nå må kommunen fjerne kabelen
Digi.no
2

Kommentar
Selv ikke «to absolutte alfaer» kan trylle
Ellen Synnøve Viseth - Kommentator
23

Telenor har milevis med kabler de ikke får bruke
Digi.no

Fikk tildelt første område for flytende havvind:
– Vi mener det er mulighet for lønnsomhet
3

Podkast
Norsk satsing på flytbatterier fra Texas:
– Det løser fundamentale problemer
5

Kreftgass:
Staten anmelder Equinor

PST har ropt om hjelp:
Justisdepartementet får slakt
1

Sjømatnæringen:
Strømnettet ikke rigget for vekst – Statnett mener de har kontroll

Kommentar
I går kom årets stussligste julegave
Kristina Fritsvold Nilsen - Ansvarlig redaktør
Digi.no
6

Google står bak gigantplaner i Østfold
Digi.no
2

Vekker reaksjoner:
– Helt uakseptabelt
Digi.no
1

Bane Nor klages inn til Jernbanetilsynet:
«Snur jernbanelovgivningens formål på hodet»
1

Snart det viktigste kampflyet i tre nordiske land
8

Kø-marerittet på Sollihøgda kan være over

Kan ha lest private SMS-er:
Varsler tilsyn mot norske mobilselskaper
Digi.no
Solcellespesialisten konkurs:
Skylder på norgesprisen

Et av de største problemene med grønt hydrogen ble plutselig svært tydelig
20

Debatt
Energi-løsningen nevnes knapt – og vi bygger over den
1
Johan Castberg-feltet:
Investerer over fire milliarder

Militær etterretning:
Ekspert vil ha Norge med i EUs nye enhet

Skal bli viktig del av:
«Trøndersk Silicon Valley»

Kjernekraftjobb til Ola Borten Moe: – Gleder meg veldig
10

Milliarder til nye havvind-prosjekter
1
Kongsberg inngår rom-samarbeid med tyske Helsing

Luftforsvaret flyr tre «julestjerner» i år

Tester Microsoft-alternativ:
«Jeg er i ferd med å bli gråhåret»
Digi.no
6
Miljøorganisasjonene:
Anker gruvedumping-sak

Få store prosjekter på norsk sokkel:
Allerede varslet nedbemanninger
2

Debatt
Kaster barna ut fra Facebook:
Teknologien vil først latterliggjøres, for deretter å levere endring
Digi.no
1

Europas gassbehov faller:
– Tror Norge blir EUs klare førstevalg
7
EU-enighet:
90 prosent kutt i utslippene

«Svært dårlig» stemning internt etter at det kuttes stort i staben
Digi.no

Bli med inn i A-blokka:
– Et eventyr og litt galskap
01:24
– Et spesielt prosjekt

Corvus inngår intensjonsavtale med kinesisk batterikjempe

– Det er aldri nok. Vi har et betydelig etterslep
1

Disse ønsker å bli toppsjef for Norges superdatamaskiner
Digi.no
Biltema-masker ga bedre beskyttelse:
Setter 100-millioners kjøp av masker til Ukraina på vent

Aibel har mistet mulige oppdrag for nær 20 milliarder
6

Vurderer å fase ut CO2-avgift – bransjen er positive
4
NVE sier ja til solkraftverk langs E6

NVE:
Vil ikke gjøre havvind-unntak for GoliatVind
2

Regjeringen forlenger fristen for å kjøpe redningshelikoptre
3

Helseplattformen må rette en rekke feil innen ti dager for å unngå dagbøter
Digi.no
1

UDI:
To superkolleger sparer dem for 130 årsverk
Digi.no
3
En av tre sliter digitalt

Noen har fått tak i e-postadressene til alle skoleelever i Bergen
Digi.no